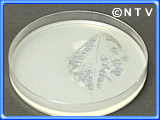
V[Ŝ̉

お刺身にそうめん・冷や麦、さらに冷奴といろいろな場面で使われているシソ。実はシソは日本でしか料理に使われない、まさに日本の食材なのです。そんな日本料理の名脇役シソですが、まだまだ様々な知られざる姿が有ったのです。
まず、シソには2種類あることをここで確認。葉が緑色の「青ジソ」と梅干し作りなどに用いる、葉が赤紫色の「赤ジソ」。この2種類のシソ、一体どこが違うのでしょうか?赤ジソの赤は、アントシアニンという、紫キャベツやブドウの皮などにも含まれている色素で、この色素が有るか無いかだけで、植物的には一緒のものでした。
そしてシソの特徴といえば、何といってもあの香り。どうしてあんなに香りが強いのでしょうか?シソの葉の表面を顕微鏡で見てみると、カプセル状のかたまりがたくさん有りました。このカプセルのようなものを油胞といい、香りのもとである精油成分が入っていたのです。この油胞、他の香りを持つ植物、たとえばショウガやミカンでは内側や皮の中にあるため、切ったりつぶしたりしなければあまり香ることはないのですが、シソは葉の表面に持っているので、少し葉をこすっただけでもこの油胞が壊れて香りが立ち込めてくるのです。
 | シソの香りの秘密は、葉の表面にあった!
|
|
皆さん、家庭菜園でシソを育てたこと有りますか?結構育てたことのある方、多いのではないでしょうか。でも、シソってすぐに虫に食われていませんでしたか?あの臭いが原因なのでしょうか?
そこでシソの葉の上に、葉を食べるのが大好きなナメクジやイモムシを乗っけてみました。しかし驚いたことにいずれの虫もさっさ逃げてしまったのです。
そこで今度はシソの香り成分ペリラアルデヒドを取り出し、それをお食事中のカブトムシの所に持っていきました。すると逃げるどころの騒ぎじゃありません!もんどりうって逃げ惑い、もう完全にパニック状態。
 いったいこんなに虫に嫌われているシソになぜ、あんなに虫食いの跡が有るのでしょう?実はハスモンヨトウというガの一種の幼虫が、その正体でした。夜行性のこの虫はキャベツなど色々な植物を食べてしまうのですが、それらの植物は他の害虫に狙われやすく、殺虫剤などで守られているため、ハスモンヨトウもなかなか近づけません。しかしシソは、その香りのためにもともと害虫がつきにくく、ハスモンヨトウにとっては敵がいないため好都合だったのです。そのためシソ農家では夏でもビニールハウスでシソを密閉し、成虫が卵を産まないように誘蛾灯を設置するなど、鉄壁のガードで守りながらシソを栽培していたのです。
いったいこんなに虫に嫌われているシソになぜ、あんなに虫食いの跡が有るのでしょう?実はハスモンヨトウというガの一種の幼虫が、その正体でした。夜行性のこの虫はキャベツなど色々な植物を食べてしまうのですが、それらの植物は他の害虫に狙われやすく、殺虫剤などで守られているため、ハスモンヨトウもなかなか近づけません。しかしシソは、その香りのためにもともと害虫がつきにくく、ハスモンヨトウにとっては敵がいないため好都合だったのです。そのためシソ農家では夏でもビニールハウスでシソを密閉し、成虫が卵を産まないように誘蛾灯を設置するなど、鉄壁のガードで守りながらシソを栽培していたのです。
お刺身に必ずシソが添えられているのは、抗菌作用が有るためと言われています。そこでイカの刺身にシソを添えたものとそうでないものを準備し、24時間後の変化を見てみました。すると、シソ有りの方も腐ってしまったのです。これは最近のシソが臭いのマイルドなものになってしまったためだといいます。
ところが、昔ながらの臭いの強いシソを和歌山で栽培しているという情報が入りました。早速向かった矢野リポーター。そこで出会った臭い一杯のシソはどんな物でしょう?これは薬として使うため、香りの強いものだけを交配して昔ながらの香りを保っていたのです。においセンサーで測ると何と普通のシソの倍の香り。このシソを持ち帰って細菌培養実験をしてみました。すると効果てきめん!24時間後、くっきりとシソの形あわせて菌が繁殖していませんでした。シソの香り、ぺリラアルデヒドには、抗菌作用があったのです。
ところが、昔ながらの臭いの強いシソを和歌山で栽培しているという情報が入りました。早速向かった矢野リポーター。そこで出会った臭い一杯のシソはどんな物でしょう?これは薬として使うため、香りの強いものだけを交配して昔ながらの香りを保っていたのです。においセンサーで測ると何と普通のシソの倍の香り。このシソを持ち帰って細菌培養実験をしてみました。すると効果てきめん!24時間後、くっきりとシソの形あわせて菌が繁殖していませんでした。シソの香り、ぺリラアルデヒドには、抗菌作用があったのです。
魚住アナウンサーが、三島由紀夫と川端康成の往復書簡を読んでいた所、“シソ糖”という名前を発見しました。なんでも戦時中、砂糖の代用品に使われていたもので、甘さは砂糖の2000倍とか。もちろん「目がテン!」のこと、再現に挑戦です。まず5kgのシソから香り成分のぺリラアルデヒドを5g取り出しました。それに製薬原料のヒドロキシアミンを加えてかき混ぜること30分。出てきたつぶつぶをろ過、乾燥させると幻のシソ糖、ぺリラルチン2.5gが完成しました。所さんもスタジオで試食です。はじめはあまり味がしないのですが、後から後から甘みが込み上げて、しかもその甘みがいつまでも口の中にとどまっているのです。所さんいわく「自分の舌がキャンディーになったみたい」。しかしこのぺリラルチン、熱に弱く、お湯に溶かすと分解してもとのシソの香りに戻ってしまうのです。コーヒーに入れても甘くなくシソの香りがするだけ…と言うことで、現在は使われていないのです。
 | シソの香りから作るシソ糖は、恐るべき甘さだった!
|
|
|
|

